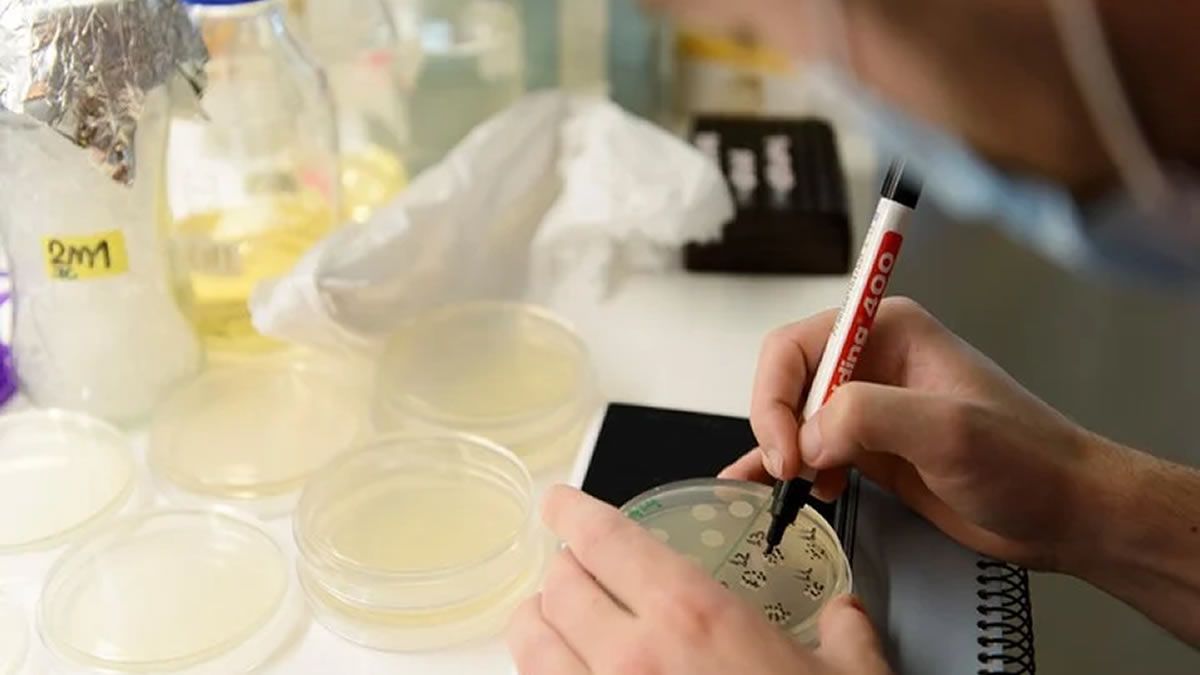

La vacuna argentina Arvac Cecilia Grierson (Arvac CG) contra el coronavirus, desarrollada por el Conicet, la Universidad Nacional de San Martín (Unsam) y el Laboratorio Cassará, "es segura y muy inmunogénica", reveló el reporte sobre los ensayos clínicos de la fase I, de los que participaron 80 personas sanas previamente vacunadas contra el SARS-CoV-2, se informó oficialmente.
Es la primera vez que una vacuna preventiva de enfermedades infecciosas diseñada y desarrollada integralmente en Argentina completa los estudios clínicos de la fase I.
"Realmente creo que son resultados muy buenos, resultados francamente positivos. Previamente en la Argentina se han producido vacunas frente al SARS-CoV-2, pero siempre con un insumo importado. Esta vacuna es distinta ya que todo el insumo se produjo desde el inicio en la Argentina y están finalizando ya la fase 1", comenzó diciendo el Dr. Jorge Geffner, investigador CONICET del Instituto de Investigaciones Biomédicas en Retrovirus y SIDA, en comunicación con LV12 Radio Independencia.
"En la fase 1 miras dos cosas, primero que la vacuna sea segura, es decir que cuando te inoculas la vacuna no te pase nada malo y realmente no hubo un solo efecto adverso importante, así que en términos de seguridad la vacuna anduvo muy bien y el segundo parámetro es inmunogenicidad, es decir te vacunas y se ve cómo levantan los niveles de anticuerpos que son los que median la protección y realmente en el parámetro de inmunogenicidad, fueron absolutamente comparables con el resto de las vacunas que ya circulan y han sido aprobadas por la comunidad europea. Tendremos una producción local muy buena", agregó.
Por otro lado, explicó que como toda vacuna la fase primera, pasó hace 10 meses. Primero una fase experimental que se las prueba en ratón básicamente, una vez que completas todo y tenés todos los parámetros de seguridad bien en modelos experimentales, recién se pasa a la fase 1 que es en personas. "Toda esta fase 1 fue desarrollada en personas y realmente los resultados son muy buenos".
"Lo interesante del ensayo este, es que siempre que creas una vacuna tenés que probarlo contra la variante convencional, la original que es la variante de Wuhan, se probó contra Delta y Ómicron", cerró.